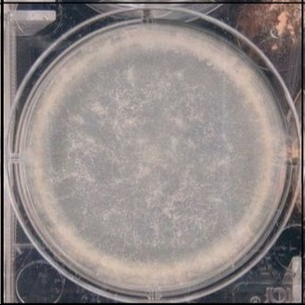

Fungal research @ Cultivarium
Explore tools and data for the fungal biology program at Cultivarium.
Fungal Culture Image Atlas
Browse time-lapse videos, growth images, and growth curves for fungal species on diverse carbon, nitrogen, and standard media panels.
Explore strains →
Codon Explorer
Explore codon usage patterns across 2,100+ fungal species, optimize gene sequences for heterologous expression, and compare codon adaptation indices.
Explore codons →
PRISM AI-Powered Protocols
PRISM is an AI-assisted laboratory protocol platform through which we are sharing protocols for fungal biology. PRISM uses AI to help researchers create reproducible, detailed experimental procedures.
Some of our fungal protocols:

Cultivarium Portal
A general resource for information and user discussion on microbial species and strains, including 72,948 species of Fungi. Sign up for access.
Visit Portal →
Fungal Ku Gene Database
Annotation and literature curation of non-homologous end joining (NHEJ) genes and knockouts across Fungi. Browse characterized Ku70/Ku80 homologs identified via HMM-based search across fungal genomes.
Browse genes →